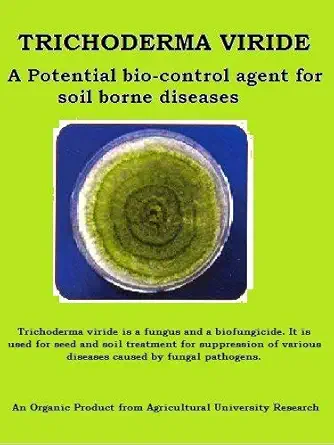
100% Organic TRICHODERMA VIRIDE (BIO-Fungicide)- 1 Kg Kerala Agro Organics

Buy Online Pesticides from BuyBestBrands.in in Association with Amazon India
Home » Garden & Outdoor » Garden & Outdoor » Gardening » Pesticides » Garden Genie Neem Cake Organic Fertilizer - 1800gm | Pest Repellent & Fertilizer for Plants
Product Description :
Garden Genies Neem Cake is a 100% Organic Fertilizer and unadulterated product derived from fruits and kernels of Neem. It is a natural combination of a Fertilizer and a pest repellent. It is a slow release Fertilizer which releases Nutrition in a controlled and long lasting manner. Neem Cake is rich in macronutrients such as Nitrogen, Phosphorus, and Potassium, and a plethora of other micronutrients. It helps in increasing the growth and leafage of plants and vegetables. It also emanates in rich blossoming, strengthening of roots and improving the general appearance of fruits and vegetables. It specializes in preventing and treating ailment disorders of plants due to imbalance of Marco and Trace elements. Garden Genies Neem Cake improves the organic content in the soil by reducing its alkalinity and producing organic acids on decomposition. Being completely natural, neem is compatible with soil microbes, improves rhizosphere microflora and ensures stronger texture, higher water holding capacity and aeration in the soil for better root development. DIRECTION TO USE: 1. Use 30 to 40 grams of Garden Genies Neem Cake per plant as soil application and subsequently 10 to 20 grams as per plants need. 2.Alternatively, you can also mix Garden Genies Neem Cake with soil and apply on and around the roots of the plants, vegetables, bushes or/and tree, and witness a remarkable result in the improvement of the plant immunity. 3. Use once in every three-four weeks Garden Genie
Product Features :
- Garden Genie's Neem Cake provides plants with essential Macronutrients in the form of Nitrogen, Phosphorus and Potassium.
- It helps in maintaining symbiotic beneficial micro-organisms in the soil, which in turn help in plant growth
- It helps plant parents and hobby gardeners take care of plants by building long term plant immunity against pests and diseases.
- It provides plants with a wide variety of nutrition including Organic Carbon, Organic Matter, Micronutrients and Beneficial Elements.
- It is a Natural Pest Killer, Antifungal & Antibacterial Product.
- It is both a preventive and curative product which is effective against a wide variety of pests and diseases.
Compare With Similar Items
Garden & Outdoor
Turn your green spaces into green. Whether it's growing your own food or decorating your home or garden with flowers or plants, there are plenty of reasons to go gardening. Explore our wide selection of seeds, watering equipment, fertilizer and soil, pots and planters, pest control, live plants, gardening tools, garden decoration, garden accessories, power tools, barbecue, organic gardening and more to help you get started.
Buy Garden and Outdoors Products Online at Buybestbrands.in India
You do not really need to have green fingers, and gardening does not come naturally to all. If you just love being outdoors, you can choose gardening as one of your hobbies. Whether you live in a detached villa with a large garden in your front or back yard or in an apartment with a balcony, you can create your own garden and relax in a carbon-free environment. Make your space a welcoming place with a nice garden and colorful flowers. Choose from top of the line garden and outdoor products from Buybestbrands.in at attractive prices, and let your ideas and inspirations go wild.
Well-Equipped Outdoors
A garden is usually a planned space, where different forms of nature are exhibited and cultivated as part of a setting. Although planning from the outside requires a lot of planning, you can work on a wide range of themes and assemble plants, fountains, lighting and other furniture, depending on your preferences. Buybestbrands.in India offers a large selection of plants and seeds as well as planters, fertilizers, tools and gardening equipment. You can also find bird baths, outdoor candles, wind chimes, garden umbrellas, sculptures and statues, as well as outdoor playground equipment. Create a paradise with planters and unique and exotic decorating ideas. Buy garden and outdoor products on Buybestbrands.in and take advantage of great offers.
Find Your Delight Outdoors
Buybestbrands.in houses a variety of garden and outdoor products, including seeds, watering equipment, fertilizers and soil, pots and planters, pest control, live plants, gardening tools, gardening accessories, gardening accessories, power tools, barbecue products, furniture green spaces and much more. Have a picnic or take your guests home to enjoy each season in the sun, with high quality garden and outdoor products placed on furniture made from materials such as wood, plastic, wood, fabrics and many others. Become a citizen of the world and offer green products such as solar chargers, sun bags, solar lights and lanterns, etc. to your friends and family. Design a safe, pure and beautiful wonderland for generations to come. Find a wide range of garden and outdoor products from leading brands at Buybestbrands.in at discounted prices, and enjoy fast delivery and easy returns.
Buy Garden and Outdoors Products Online at Buybestbrands.in India
You do not really need to have green fingers, and gardening does not come naturally to all. If you just love being outdoors, you can choose gardening as one of your hobbies. Whether you live in a detached villa with a large garden in your front or back yard or in an apartment with a balcony, you can create your own garden and relax in a carbon-free environment. Make your space a welcoming place with a nice garden and colorful flowers. Choose from top of the line garden and outdoor products from Buybestbrands.in at attractive prices, and let your ideas and inspirations go wild.
Well-Equipped Outdoors
A garden is usually a planned space, where different forms of nature are exhibited and cultivated as part of a setting. Although planning from the outside requires a lot of planning, you can work on a wide range of themes and assemble plants, fountains, lights and other furniture, depending on your preferences. Buybestbrands.in India offers a large selection of plants and seeds as well as planters, fertilizers, tools and gardening equipment. You can also find bird baths, outdoor candles, wind chimes, garden umbrellas, sculptures and statues, as well as outdoor playground equipment. Create a paradise with planters and unique and exotic decorating ideas. Buy garden and outdoor products on Buybestbrands.in and take advantage of great offers
Find Your Delight Outdoors
Buybestbrands.in houses a variety of garden and outdoor products, including seeds, watering equipment, fertilizers and soil, pots and planters, pest control, live plants, flowering tools and more. gardening, garden accessories, gardening accessories, power tools, BBQ products, furniture and much more. Have a picnic or take your guests home to enjoy each season in the sun, with high quality garden and outdoor products placed on furniture made from materials such as wood, plastic, wood, fabrics and many others. Become a citizen of the world and offer green products such as solar chargers, sun bags, solar lights and lanterns, etc. to your friends and family. Design a safe, pure and beautiful wonderland for generations to come. Find a wide range of garden and outdoor products from leading brands at Buybestbrands.in at discounted prices, and enjoy fast delivery and easy returns.
Buy Flower Seeds Online for a Colorful Sight in Your Garden
Are you one of those with green fingers? So, here is good news for you. You can now buy seeds online instead of going to the nursery. As plant lovers, we can all be different. While some people love to grow their own vegetables in their garden, others love the scent of Italian herbs on the windowsill. There are others, for which nothing beats the sight of a garden with colorful flowers. If this is true in your case, all you have to do is buy flower seeds online to find a variety that you will surely love. Brands like Amir Enterprises, National Gardens, Rainbow and Priyathams offer a range of online flower seeds that you can buy depending on the type of look you want in your garden. You have rose seeds, jasmine seeds, marigold seeds and more for a variety that you can enjoy by cultivating and admiring. That being said, let's take a look at some of the things you can keep in mind when buying flower seeds online:
Indoor vs Outdoor Flower Seeds
We are not all privileged to cultivate a huge flower garden that runs the length of the patio. But do not worry. When shopping online for flower seeds, you'll also find a range of indoor seeds that you can buy to grow beautiful flowers on your balcony or kitchen. These are seeds that do not really need sunlight. So you can easily use them to plant flowers in any room. Rainbow, Priyathams and M-Tech are a few indoor flower seeds brands that you can check online to find roses, jasmine and even lotus seeds that you can grow inside your own home.
Plants
Shop from our wide selection of Bonsai, Bamboo, Cacti & Succulents, Flowers, Ferns, Orchids, Medicinal plants, Ornamental & Shade trees, Roses and more to help you get started.
We often do not think about buying plants online. But what if we tell you that you can now order the most beautiful plants right from your home? Buybestbrands.in presents a wide range of live plants that can be purchased online in India. Our collection includes annual flowers, aromatic and aquatic plants, cacti, bonsai, ferns, indoor and outdoor plants, landscape plants, bamboo, etc. Buy online at Buybestbrands.in will be beneficial, as you can see and then choose the factory you want to order. Secondly, all plants are exactly the same as those shown in the image and are ready to be used. All plants are reasonably priced and come with design and placement tips. So, whether you're planning to give a plant to your loved ones or to this wise gardener friend, Buybestbrands.in is an ideal destination for buying plants and plant care products online.
Buy Outdoor Power Tools on Buybestbrands.in India
Looking for outdoor power tools that make lawn and garden work easier? Try Buybestbrands.in India and choose the necessary tools at prices that easily fit your budget.
Are you a person who believes in the cleanliness of the lawn or garden? Hate to see the herbs invade all parts of space? In this case, you would be surprised to find, buy and use a range of power tools specifically designed for outdoor work. Choose an electric brushcutter or chainsaw, you'd be happy to use the same thing for a variety of work at home.
Give That Perfect Look to Your Lawn or Garden
A house with a lawn is more beautiful and more attractive than one that does not have one. If you grow more flowers and plants, you can easily catch the eyes of visitors to your space. How about mowing the lawn with an efficient electric brushcutter such as the STIHL FSE-81 (Orange) electric trimmer or the STIHL FSA-65 battery powered edger (charger and battery included)? These products are very easy to use and are now available at really reasonable prices.
Choose from a Range of Other Outdoor Power Tools
Buybestbrands.in India makes it easy and allows you to choose and own different types of outdoor power tools without having to spend a lot of money. You can choose from products such as electric hedge trimmer, high pressure cleaner, etc. Buybestbrands.in India also offers a range of other utility products such as a hand-held metal detector, a scanner with beep and vibrator, an electric fan, a cutlery cleaner, a car wash, etc.
Products from Top Brands to Choose from
Buybestbrands.in India brings you several external power tools from leading brands such as Turner Tools, Robotouch, Bosch, AL-KO, Josch, Stihl, Taurus Agritech, Maruti Udyog Lawn Mowers and many more. Safe and reliable tools ensure you always have a good time when doing lawn and garden maintenance.
Buy Outdoor Power Tools Online and Save Your Money
Buybestbrands.in India is your reliable online shopping destination where you can buy a variety of outdoor power tools at very competitive prices. On our website and our mobile app, you can benefit from various offers and discounts. So, what is the wait? Try Buybestbrands.in India and get the best range of outdoor power tools delivered to your home without any problem.
Gardening Accessories
Shop from our wide selection of Garden aprons, Gloves, Seed boxes & Organizers, Gardening trowels, Gardening stools, Tool holders, Germination trays and more to help you get started.
Buy Mosquito Nets Online:
We can not even count the number of times our sleep has been disturbed or irritated by mosquitoes. A mosquito seems to be a tiny, harmless insect that you can eliminate with your hand. But it's not so simple, is it? This can be the case if you bring a mosquito net home. Different models of mosquito nets for beds are available online. In addition to having the appropriate bed linen, the mosquito net is an essential accessory for the furnishing of your home. The danger posed by mosquitoes is very real. Diseases such as malaria and dengue have killed thousands and even killed many people. So, how do you protect yourself against mosquitoes and protect your family from the damage they cause? - by choosing a mosquito net of good quality for your bed of course. Brands such as Creative Textiles, Classic, LooMantha, Healthgenie and Anand India offer high quality and durable mosquito nets that provide the necessary protection.
Mosquito Nets - For Your Health and Safety:
A good amount of sleep is necessary so that anyone who stays healthy and energetic can spend the day. But if you're staying in a mosquito-infested area, you should buy a mosquito net online and protect yourself from irritation, itching and potential disease. A mosquito net is not only useful for your home. When traveling in a warm and humid place, mosquito nets are not only recommended, but also indispensable. Depending on your specific needs or the size of your bed, mosquito nets come in different designs.
Shop online for Baby’s Mosquito Nets and other Mosquito Protection products at Buybestbrands.in
Today, the mother has trouble raising her child without major health problems. Faithful to this maxim, "Prevention is better than cure," she strives to keep her child healthy, far from diseases and illnesses. The biggest nuisance it encounters is Mosquito, which spreads diseases such as malaria and dengue, which have become very common and widespread. We must continue to look for ways to keep children away from these common diseases by researching various methods and products on the market. The harmless mosquito net is not only the most basic and basic tool for mosquito control, but also the most effective and widely used mosquito protection worldwide. Buybestbrands.in offers an astonishing range of mosquito protection products for both children and adults. Choose from a wide variety of mosquito nets, from basic foldable awning to double mosquito nets, to baby crib tents with mosquito nets, mosquito patches and sprays, mosquito traps and a host of other products for effective protection Stay away from threats such as dengue and malaria. You may be spoiled for choice of mosquito protection products on Buybestbrands.in.
Long-lasting Mosquito Nets
A foldable, canopy-type mosquito net made of high-quality durable materials that can be used on the bed or on the floor and protects against mosquitoes is the most common vision in any household with a baby. This foldable mosquito net is easy to install, protects you from mosquito bites and keeps you away from malaria and dengue fever. Browse Buybestbrands.in to discover a wide variety of this basic foldable mosquito net cover, in different colors and materials, and choose the one that suits you best. An interesting variation is the Pop-Up mesh mosquito net cradle, which provides a safe and insect-free sleeping space for your baby. A portable, ultra-lightweight travel cradle with breathable, clear-vision mesh allows air to circulate freely and a clear view of your baby, even when zipped. In addition to the normal rectangular mosquito nets, which are used most often, and those that exist in a multitude of sizes, styles and colors, available on Buybestbrands.in; Try the Twist & Fold Single Mosquito Net for your double bed, if you live in a high-risk area or when traveling, providing essential protection against mosquitoes, flies and other insects. Convenient and easy to use, folded, it fits in an easy to carry case. Look for the baby crib tent with mosquito net, which is a full crib with mattresses and pillows, and a mosquito net in the form of a tent.
Choosing the Right Rat Killer Product
Place Packets / Bait Blox: Packages and Blox are placed in activity zones: crawl spaces, attics, behind appliances, etc. Rodents usually leave the structure before dying, but there is a chance that they will die inside the structure, sometimes an empty wall. Should not use where children or pets can access packages. Rat Bait Station: Station with a childproof lid that contains a block of poison inside. For use outdoors or indoors where children or pets may be able to access them. The rat will enter the station, eat bait and may die inside the station or nearby. Glue Panels: For use in cabinets, corners or along walls where rodents move. Rodents stay on board and are unable to move. Snap Traps: For use in cabinets or corners. Rodents trigger the trap by attacking food.
Many bird species in India are good to have around, because of their attractive plumage and captivating song. However, when a large number of birds congregate at a nesting site, this can have serious consequences such as:
Contamination of raw materials and finished products, resulting in loss of income.
Birds can cause material damage by dislodging roof tiles, blocking the gutter system with their nest and leaving feces that corrode building materials.
Risks to the safety of employees and customers - slippery bird droppings can cause slipping and falling accidents.
Suspension of activities and audit failures due to poor hygiene observed during the inspection.
Contamination of foods that may lead to the closure or suspension of companies by public health authorities.
Negative impact on the image and reputation of the company.
The awful sight of bird droppings can discourage potential customers from being condescending.
Bird droppings can fall on customers, leading to negative reviews of bad experience and potentially complaints.
Birds can become aggressive and attack employees or customers, especially during the breeding season when defending their young.
Bird control solutions
While most birds in their natural environment are perfectly harmless, they can harbor more than 60 communicable diseases, including salmonellosis, encephalitis and cryptococcosis. In addition to representing a potential danger to people's health, they can also put your business at risk. Early detection and effective deterrence methods by a pest control expert are the key to getting rid of bird infestation.
Buy Barbecue Skewers Online from Buybestbrands.in India
If you want to grill it on a stick, shop for barbecue skewers online from Buybestbrands.in India.
Want to eat skewers? Want to try cooking at home? Then buy barbecue skewers online from Buybestbrands.in India. It is an essential barbecue accessory, available in two types: metal and bamboo, many trusted brands such as Ezee, UPI, Norpro, Mustard, Chef Craft, Lifetime Brands, etc. If you like to cook oriental dishes, opt for bamboo skewers, because preparing such delicate foods requires shorter cooking times. But for large pieces of meat and fish, metal skewers are the best choice because the metal transfers heat to the center of the food, reducing cooking time. Whatever your needs and requirements, you are sure to find the right barbecue kebab online at Buybestbrands.in India.
Enjoy Meat on a Stick with Barbecue Skewers from Buybestbrands.in India
Whether at the beach, in a park or in your own yard, barbecues are always fun outdoor activities that everyone can enjoy. And to savor the best barbecue food, you need the right kind of kebabs. On Buybestbrands.in India, you can choose options such as Ezee Kebab Wooden Skewers / Satay Sticks / 10 Inch BBQ Sticks, anne -kee Steel BBQ Sticks Skewers for BBQ Tandoor Grill 16 Inch Barbecue Skewers, White (Set of 6) , Chef Craft Stainless Steel Barbecue Skewer Set, 4 Piece, 12 Inch Farberware Professional Stainless Steel Skewers, 4 Browne Foodservice 12RS Stainless Steel Skewers Set, etc.
Buy Barbecue Skewers to Relish Deliciously Grilled Vegetables
If you buy metal skewers, make sure they have a flat blade. Smooth, round blades are useless because if you try to turn them around, they can turn around in food, making them impossible. If you buy heat-resistant sleeveless skewers, be sure to use them with mittens. Bamboo skewers are cheaper and come in many sizes. You can buy the longest for skewers and the smaller ones for preparing food to seal the stuffing. To avoid burns and burns, it is essential to soak the bamboo skewers for at least 30 minutes before using them.
Buy Thermometers at Buybestbrands.in India
The fever in babies can increase rapidly, which will probably scare parents or caregivers. It is important to monitor the fever accurately and determine if the baby needs medical treatment depending on the temperature of his body. Thermometers are the best way to record temperature readings accurately. You can choose from different types of thermometers, including oral, ear, rectal and frontal thermometers to detect your baby's temperature. Online thermometer shopping allows you to compare the features and prices of the different types of thermometers available online. Buybestbrands.in India allows you to filter search results on the web page to find thermometers by product type, brand, price, discount, etc. You can choose a thermometer depending on the type or duration for accurate reading. Generally, the front and ear thermometers are able to detect the temperature in 1 to 3 seconds. Digital thermometers to be used orally, in the rectal area or under the armpits are able to detect the temperature within 10 seconds. Choose a thermometer to suit your needs and your budget to help you determine your baby's body temperature.
Shop Thermometers Online, Find the Best Means to Monitor Body Temperature
For a newborn or toddler who is very hot, parents or caregivers may want to take frequent temperature readings at night to help them rest. However, the temperature of older children or adults may be less common day or night. You will need to determine for whom you are buying the thermometer. You will also need to consider other aspects of the thermometer, including the degree of intrusion. Digital thermometers that can record readings can be especially useful when you are monitoring the body temperature of a person with a chronic disease. Digital thermometers with disposable probe caps are preferable when looking for a thermometer for the whole family. On the other hand, you can invest in different thermometers so that each member of your family can perform readings according to their comfort, for example under the arm or orally. Having a good thermometer at home makes life easier for the new parent. Those looking for a reliable thermometer to record temperature can also choose to shop thermometers online. If you have trouble choosing from a myriad of options, it's a good idea to go through a few products from the rectal, underarm and mouth thermometers to find a good thermometer. Consider the features that matter most to you, including price and ease of use, before you focus on the thermometer. Buybestbrands.in India offers a wide selection of online thermometers of various brands including Omron, Dr. Morepen, Easy Care, etc.
Choose Between the Types of Thermometers
Consider this, not all thermometers work well for all ages. Rectal thermometers are recommended for neonates, but may be uncomfortable for older children. Oral thermometers are recommended for children over 4 years old. Which thermometer works best for your child? You will have to consider the behavior of your child, for example, if he is uncomfortable, it is unlikely that you get an accurate reading with an ear or rectal thermometer. For a family with a wide range of ages, you can consider several thermometers. Buy online at Buybestbrands.in India and choose from a wide range of online thermometers. Be sure to store the thermometer properly for proper operation.
Popular Categories on BuyBestBrands.in
Garden & Outdoors : Seeds, Plants, Plant Containers, Gardening Tools, Garden Decor, Pest Control, Barbecue & Outdoor Dining, Solar Power, Fertilizer & soil, Watering Equipment
Amazon Brand : Symbol, Inkast Denim Co, House & Shields, Jam & Honey, Solimo, Presto!, Symactive, Eden & Ivy, Vedaka, Tavasya, Myx


 699
699 325
325